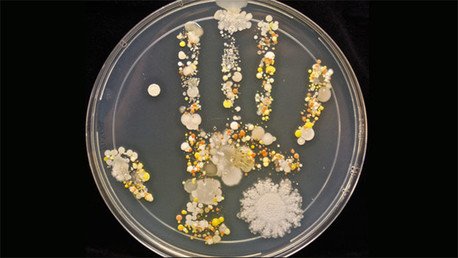
FOTO: ¿Cómo son realmente las bacterias de unas manos sin lavar?

Según Sturm explica en una entrada en Microbe World —el portal de la Sociedad Estadounidense de Microbiología—, donde también publicó la impresionante foto, la imagen fue tomada después de que el niño hubiera estado jugando en la calle.
LEA TAMBIÉN: Alertan que los dispositivos móviles albergan más gérmenes que un inodoro
Para conseguirla, la científica usó una placa de Petri, un típico recipiente redondo de cristal que sirve en microbiología para cultivar células u observar la germinación de las semillas. Tomó la placa estéril y agar tripticasa de soja, utilizado para el cultivo de bacterias, y presionó suavemente los dedos y la palma de su hijo para que hicieran contacto con el agar.
Luego, cubrió la placa y la colocó en una incubadora a la temperatura del cuerpo humano (unos 37 grados) durante un día, aunque dice que también se puede dejar de esta manera 48 horas. A continuación dejó la placa a temperatura ambiente (unos 22 grados) durante unos días más.
El resultado pasada una semana fue una obra de arte llena de color que puso al descubierto millones de microorganismos que residen sobre nuestra piel silenciosamente.